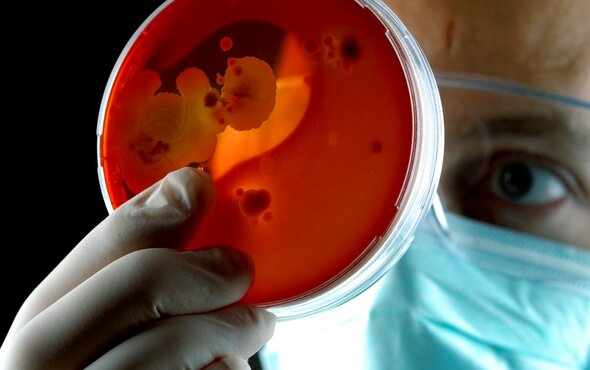

Eine kleine Anekdote gefällig? Eine Berufsfeuerwehr – irgendwo in Deutschland. Dort, wo die Feuerwehrleute auch Rettungswagen fahren. Ein Vertreter kommt vorbei, der den Entscheidern bei der Berufswehr einen Notfallkoffer präsentiert. Er spricht lange, preist dessen Vorzüge. Einer der Feuerwehrleute stellt den Koffer auf den Boden und springt mit beiden Füßen darauf. Der Koffer ist verbeult. Der Feuerwehrmann beugt sich, hebt den Koffer auf, drückt ihn dem Vertreter in die Hand. Ruhig bemerkt er: „DAS ist NICHTS für Feuerwehrleute“.
EINSATZZAHLEN STEIGEN – RESSOURCEN WERDEN KNAPP
0 oder 1. An oder aus. Mehr braucht es nicht, wenn man unter Lebensgefahr Technik anwendet. Reagiert wird instinktiv. Zum Einsatz kommen nicht nur Menschen für Menschen. Zum Einsatz kommen auch Reflexe. Dem wird grundsätzlich Rechnung getragen, indem Feuerwehren „eigentlich“ gut ausgestattet sind.

Monique Breithaupt-Peters (Diplom-Psychologin, Coach, Trainerin und Feuerwehrfrau) weiß allerdings, dass Feuerwehrleute auch manchmal Fünfe gerade sein lassen beim Umgang mit der Persönlichen Schutzausrüstung: „Oft fehlen für das richtige Verhalten auch einfach die Ressourcen. Feuerwehrleute befürchten durchaus, beim nächsten Einsatz keine Ausrüstung zu haben, wenn sie die Kleider zum Waschen geben. In Zeiten rasant steigender Einsatzzahlen und zunehmender Brandmeldeanlagen ist das ebenfalls ein großes Thema, gerade weil sich die Feuerwehrleute ihrer Aufgabe sehr verpflichtet fühlen“.
Als Psychologin hat Monique Breithaupt-Peters dafür auch eine Erklärung: „Wenn Gefahren nicht unmittelbar spürbar sind, reagieren wir großzügig. Das geht vielen von uns so – auch Nichtfeuerwehrleuten. Das Erleben im Moment ist das, was modulierend auf unser Verhalten wirkt. Bei den langfristigen Folgen denkt jeder: Das passiert nur den anderen!“
MENSCHEN IM EHRENAMT GEHÖREN GEWÜRDIGT
Um knappe Ausrüstung nach einem Einsatz hygienisch aufzubereiten, stehen gerade bei Freiwilligen Feuerwehren häufig ehrenamtliche Kameraden stundenlang in der Atemschutzwerkstatt oder an der Schlauchwaschanlage. Und das sind keine guten Aussichten für Menschen, die sich ihre ohnehin schon knapp bemessene Freizeit für den Dienst an der Allgemeinheit frei halten – ein Ressourcenproblem völlig anderer Natur stellt sich dar.
Das weiß auch Frank Bauer, der als Kommandant gleich vier Ortsteil-Feuerwehren der Gesamtwehr im baden-württembergischen Pfinztal vorsteht: „Wer versucht, Menschen für ein Ehrenamt zu begeistern, der ist froh, wenn ihn dabei effiziente Technik unterstützt“. Der Feuerwehrkommandant spielt mit dieser Aussage auf die Anschaffung des TopClean M für seine Feuerwehr an. Für die maschinelle Reinigung der Atemschutztechnik gab es bei ihrer Anschaffung nämlich ein ganz besonderes Motiv laut Frank Bauer: „Wer Menschen für ein Ehrenamt begeistern will, muss ihnen die Arbeit dafür so leicht wie möglich machen!“


WIN-WIN: KOOPERATION ZWISCHEN INDUSTRIE UND FEUERWEHR
Die beiden Faktoren „Ausrüstung in ausreichendem Maße“ und „Schnelligkeit bei deren Aufbereitung“ spielen allerdings nicht nur bei Freiwilligen Feuerwehren eine große Rolle. Auch in der Industrie ist Atemschutztechnologie in Gebrauch, die aufbereitet sein will. In der Stadt Bramsche sind Industrie und Feuerwehr dabei eine Kooperation eingegangen, die als Vorbild für Corporate Social Responsibility gelten könnte.
Man darf es getrost auch die „Soziale Verantwortung eines Unternehmens“ nennen. Das Entsorgungsunternehmen Remondis, seit Ende der 60er Jahre in der niedersächsischen Stadt ansässig, übernimmt die Sammlung, den Transport und die Verwertung voller und leerer Spraydosen sowie von Spezialchemikalien, wenn diese besonders gefährlich und giftig sind. Im Unternehmen müssen pro Woche rund 30 Industriemasken aufbereitet werden. Das klingt nicht nach viel, bindet jede Woche aber immerhin einen Mann-Tag.
EIN MANN-TAG – ZWEI MONATSGEHÄLTER – EINE SAUBERE LÖSUNG
Seit einiger Zeit geschieht die Aufbereitung in der Atemschutzwerkstatt der Feuerwehr in Bramsche. Deren hauptamtlichem Atemschutzgerätewart Jörg Reinhardt und Ortsbrandmeister Jörg Ludwigs ist das besondere Joint Venture zwischen Remondis und der Feuerwehr zu verdanken. Sie rechneten zusammen mit Jörg Repetzky, Vertriebsaußendienstmitarbeiter bei MEIKO und kamen zu folgendem Ergebnis: „ Wir haben errechnet, dass dieser eine Mann-Tag pro Woche auf ein Jahr gesehen rund zwei Monatsgehälter ausmacht. Danach war schnell klar, dass Remondis sich mit dem Kauf des TopClean M für die Feuerwehr, die dann wiederum die Dienstleistung für das Unternehmen erbringt, eine ökonomisch sinnvolle Lösung schafft“, so Jörg Repetzky von MEIKO.
Neben Ökonomie und Schnelligkeit stehen bei einem anderen großen deutschen Industrieunternehmen vor allem Sicherheit und Komfort bei der Maskenaufbereitung im Mittelpunkt. Lesen Sie hier wie Aurubis seinen Mitarbeitern in der Atemschutzgerätewerkstatt mehr Arbeitssicherheit und ein ergonomischeres Arbeiten beim Aufbereiten der Masken ermöglicht.